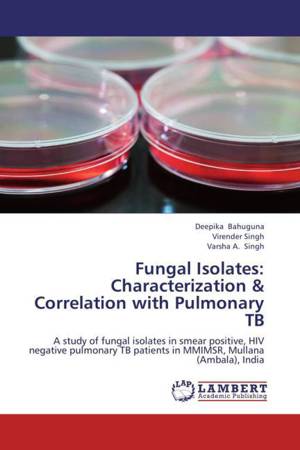

- Afhalen na 1 uur in een winkel met voorraad
- Gratis thuislevering in België vanaf € 30
- Ruim aanbod met 7 miljoen producten
- Afhalen na 1 uur in een winkel met voorraad
- Gratis thuislevering in België vanaf € 30
- Ruim aanbod met 7 miljoen producten
Zoeken
Resultaten voor "Varsha A. Singh"
-
Prevalance of Group A Streptococcus among healthy children
Sunil Shekhar Ghimire, V. K. Narang, Varsha A. Singh
- Paperback | Engels
- Acute pharyngitis is a common illness in children and adults. Its etiology includes a wide variety of microbial agents. Group A Streptococci (GAS) are... Lees meer
€ 64,45Levertermijn 1 à 4 weken€ 64,45Levertermijn 1 à 4 weken -
Fungal Isolates: Characterization & Correlation with Pulmonary TB
Deepika Bahuguna, Virender Singh, Varsha A. Singh
- Paperback | Engels
- Tuberculosis (TB) is one of the oldest diseases known to affect humans, caused by number of bacteria of genus Mycobacterium and is a major cause of de... Lees meer
€ 64,45Levertermijn 1 à 4 weken€ 64,45Levertermijn 1 à 4 weken -
In-use tests for hospital disinfectants and antiseptics
Kamal Jeet, P. S. Grover, Varsha A. Singh
- Paperback | Engels
- Disinfectants and antiseptics play a vital role in the infection control. They act as a crucial armament against transmission of nosocomial infections... Lees meer
€ 37,95Levertermijn 1 à 4 weken€ 37,95Levertermijn 1 à 4 weken -
Isolation of Mycobacterium tuberculosis
Priya Mehrishi, Shinu Pottathil, Varsha A. Singh
- Paperback | Engels
- The study was designed to compare the efficacy of cetylpyridinium chloride (CPC) and sodium chloride (NaCl) decontamination method with N-acetyl L-Cys... Lees meer
€ 47,95Levertermijn 1 à 4 weken€ 47,95Levertermijn 1 à 4 weken -
Nitrate Reductase Assay- For Detection of MDR Tuberculosis
Rumana Farooq Mir, Varsha A. Singh, Shinu Pottathil
- Paperback | Engels
- Tuberculosis remains a major health problem worldwide. Further, the incidence of TB is complicated by the increasing incidence of MDR strains of TB ba... Lees meer
€ 61,45Levertermijn 1 à 4 weken€ 61,45Levertermijn 1 à 4 weken -
Bacterial Isolates & Characterization: Post Surgical Wound Infections
Pooja Singh Gangania, Varsha A. Singh
- Paperback | Engels
- Post-operative wound infections have been found to pose a major problem in the field of surgery for a long time and it includes the wounds that drain ... Lees meer
€ 49,95Levertermijn 1 à 4 weken€ 49,95Levertermijn 1 à 4 weken
6 van 6 resultaten getoond